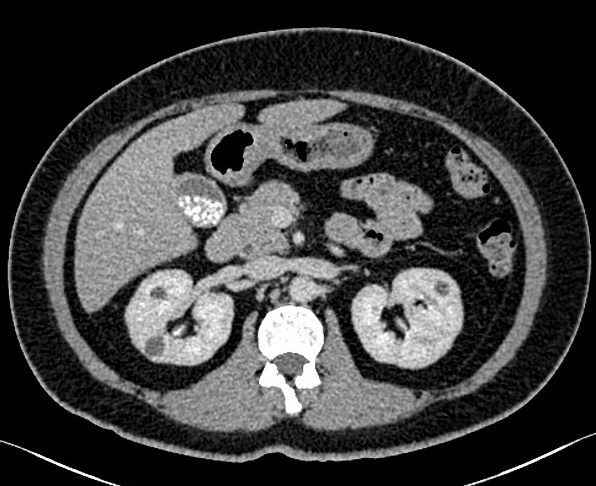

|
-
La vesicule biliaire et des voies biliaires
sont ensemble des cannaux collectant la bile synthetisee
dans le foies et ecoulement jusqu'au dans le duodenum .Affections de
cettes voies sont frequentes , sa pathologie est multiple et
variee : inflamatoire , infectieuse , tumorale et ...Imagerie
de cette voie est incontournable en faire de l'exploration
Pathologie radiologique de voie biliaire accessoire ( Canal
cystique et vesicule biliaire ) :
Lithiase
vesiculaire : La lithiase biliaire
est une pathologie tres frequente , souvent
asymtomatique Il y avait trois type de
lithiase vesiculaire : calcul cholesterolique ( 10% ) calcul pigmentaire (
10% ) forme mixtes ( 80%) . Il se presente le plus
souvent apres 60-70 ans , Sex feminin est 2 fois de plus que
l'homme , grossesse et obesite sont des facteurs
favorisantes . Les medicaments hypolipidemiants(clofibrate)
, les contraceptif oraux , la maladie de Crohn , la
mucoviscidose et les diabete .. sont ainsi des facteurs de
favosise a la formation des calculs
Images de ASP :
Seul 20% calcule des voies biliaires est radiopaque ce qui peut
en voyait sur le cliche de face ASP . Situe a
hypochondre droit en forme de calcul seul , en deux et
multiple ,en forne arrondie ou ovalaire , contour radioopaque et hyperclate centrale
" Mercedes -Benz sign"ou en forme de
vmultiloculaire
| |
 |
|
 |
|
| |
Image radiologique une
calcul radioopaque de la vesicule biliaire . En
forme arrondie , ovalaire seul , situe a la region
hypochondre droit |
|
Ou image de contour
radioopaque et hyperlucence central "
Mercedes-Benz sign " |
|
| |
 |
|
 |
|
| |
Image une calcul de la
vesicule biliaire situe a hypochondre droit
multilobulaire et a bord lisse . Cliche de face ASP
. |
|
Mene cas en ASP
de profile droit . Image du calcul situe
avant du corp vertebrale L3 |
|
| |
 |
|
 |
|
| |
Image
radiologique ASP d'une calcul de la vesicule
biliaire cholesterolique |
|
Lithiase vesicule biliaire multiple se forment par la saturation de la bile en cholestérol et
par la
précipitation les cristaux de cholestérol  .
Image de calcul cholesterolique de la vesicule
biliaire |
|
| |
|
|
|
|
| |
|
|
|
|
Image echographique
:
C'est la technique de la premier de l'intention pour
explore de calcul vesiculaire , sa sensibilite et sa specifilite
est tres bonne de donnee des signes direct ou indirecte des
voies biliaire intrahepatique( VBIH ) ou des voie biliaire
pricipale ( VBP) . Images echographique direct de
calcul vesiculaire est image hyperechogene en forme C
inverse ,avec de vide aoustique posterieure , sa nombre , la
taille est varie .Localisation peut mobilisee quand on a change
position du maladie " rolling stone sign "
- Image de artefact de scintillement peu obverve
sur echo en Doppler de petit calcul . Resemble une queue de
commet
- Singe de complication ou sign indirect de
calcul vesiculaire est dilatation et epaissisement parietal
de VBIH et VBP ( signe de obtruction )
| |
 |
|
 |
|
| |
Petite calcule a
infundibulum de la vesicule biliaire . Coupe
echographique recurrent a hypochondre droit |
|
Calcul vesicule biliaire :
Image hyperechogene de 10mm en C forme
avec espace de
vide ascoustique posterieure en voyant tres fine .
Image echographique du foie |
|
| |
 |
|
 |
|
| |
Image echographique
hyperechogene de deux calculs de la vesicule
biliaire . Cone de l'ombre sont en vue tres net |
|
Image de hypoascoustique posterieure de
calcul est toujour en se presentee . Meme cas
en un autre plan de coupe |
|
| |
 |
|
 |
|
| |
Lithiase vesiculaire multiple
situe a infudibulum de la vesicule biliaire .
L'ombre acoustique de vide posterieure est tres
large . |
|
Les petits calculs vesiculaire peut se
donne de images de artefact brilliant posterieure "
twinkle artefact " . cette artefact peut en voyait
meme sur les calculs renals , et de la vessi |
|
Image TDM :
Selon de la propiete des calculs vesiculaires ,
calcique ou cholesteolique ,les calculs vesiculaires se donne
de image hypodense ( cholesterolique ) ou hyperdense (
calcique ) que la bile . Quel que calcul biliaire peut done
de image a isodense avec la bile de la vesicule biliaire .
Image de epaissisememnt parietale et dilatation de voies
biliaire peut se en voyait
Image de cholangio -TDM
| |
 |
|
 |
|
| |
Calcul
vesiculaire de type pigmentaire en coupe
TDM axiale a non contrast . Forme arrondie a contour
calcique hyperdense et radiolucence a hypodense
centrale . La vesicule biliaire est pres isodense
avec le foie |
|
Image radiologique TDM en
coupe axiale de contrast intra veineuse . Calcul
pigmentaire de la vesicule biliaire , le foie en
contrast est hyperdense que la vesicule biliaire ,
paroie de la vesicule et canall cystique se en
voyant nette |
|
| |
 |
|
 |
|
| |
Calcul arrondie hyperdense a
infundibulum de la vesicule biliaire . Vesicule est
distendue , paroi epais et oedeme ( cholecystite ) .
Image TDM , coupe axiale , contrast intraveineuse |
|
Meme cas en coupe frontale
(coronal ) |
|
| |
 |
|
|
|
| |
Images hyperdense multiple de calcul
vesicule biliaire , Coupe TDM
frontal (coronal ) de contrast intraveineuse . |
|
Meme cas en coupe
axial . Les calculs sont multiple a hyperdense dans
la vesicule hypodense que le foie |
|
Image IRM et
cholangio -IRM ( MRCP ) : Image de calcul
de la vesicule biliaire est lacule a hyposignal dans
la vesicule remplie de liquide hyperintense
| |
 |
|
 |
|
| |
Calcule vesicule biliaire
hypointense a infundibulum de la vesicule
hyperintense . Image IRM ponderee en T2 coupe axiale
|
|
Image radiologique
cholangio -IRM : Image de la lithiase est lacule
hypointense a interieure la vesicule remplie de bile
hyperintense . Voie biliaire pricipale , voie
intrahepatique et canal de Wirsung en voyait
complete et nette |
|
| |
|
|
|
|
Diagnostic
differentiel :
| |
- Polyp vesiculaire |
| |
- Carcinoma de la vesicule biliaire |
| |
- Boue vesiculaire |
Complication
de lithiase vesiculaire :
Complications aigues de calcul vesicule biliaire sont
Distention vesiculaire , cholecystite aigue , cholecystite
gangreneuse et perforante . Complication chronique de calcul
vesiculaire sont cholecystite chronique , fistule bilio-digestive
, syndrome de Mirizzi et cancer vesiculaire .
e
Page :
1
/
2
/
3
/
4
/
5
/
6
/
7/
8 /
9
/
10
/11/
12
A suivre
<<
PREVIOUS
<<
>> NEXT >>
Gs Bui Binh Tho
|